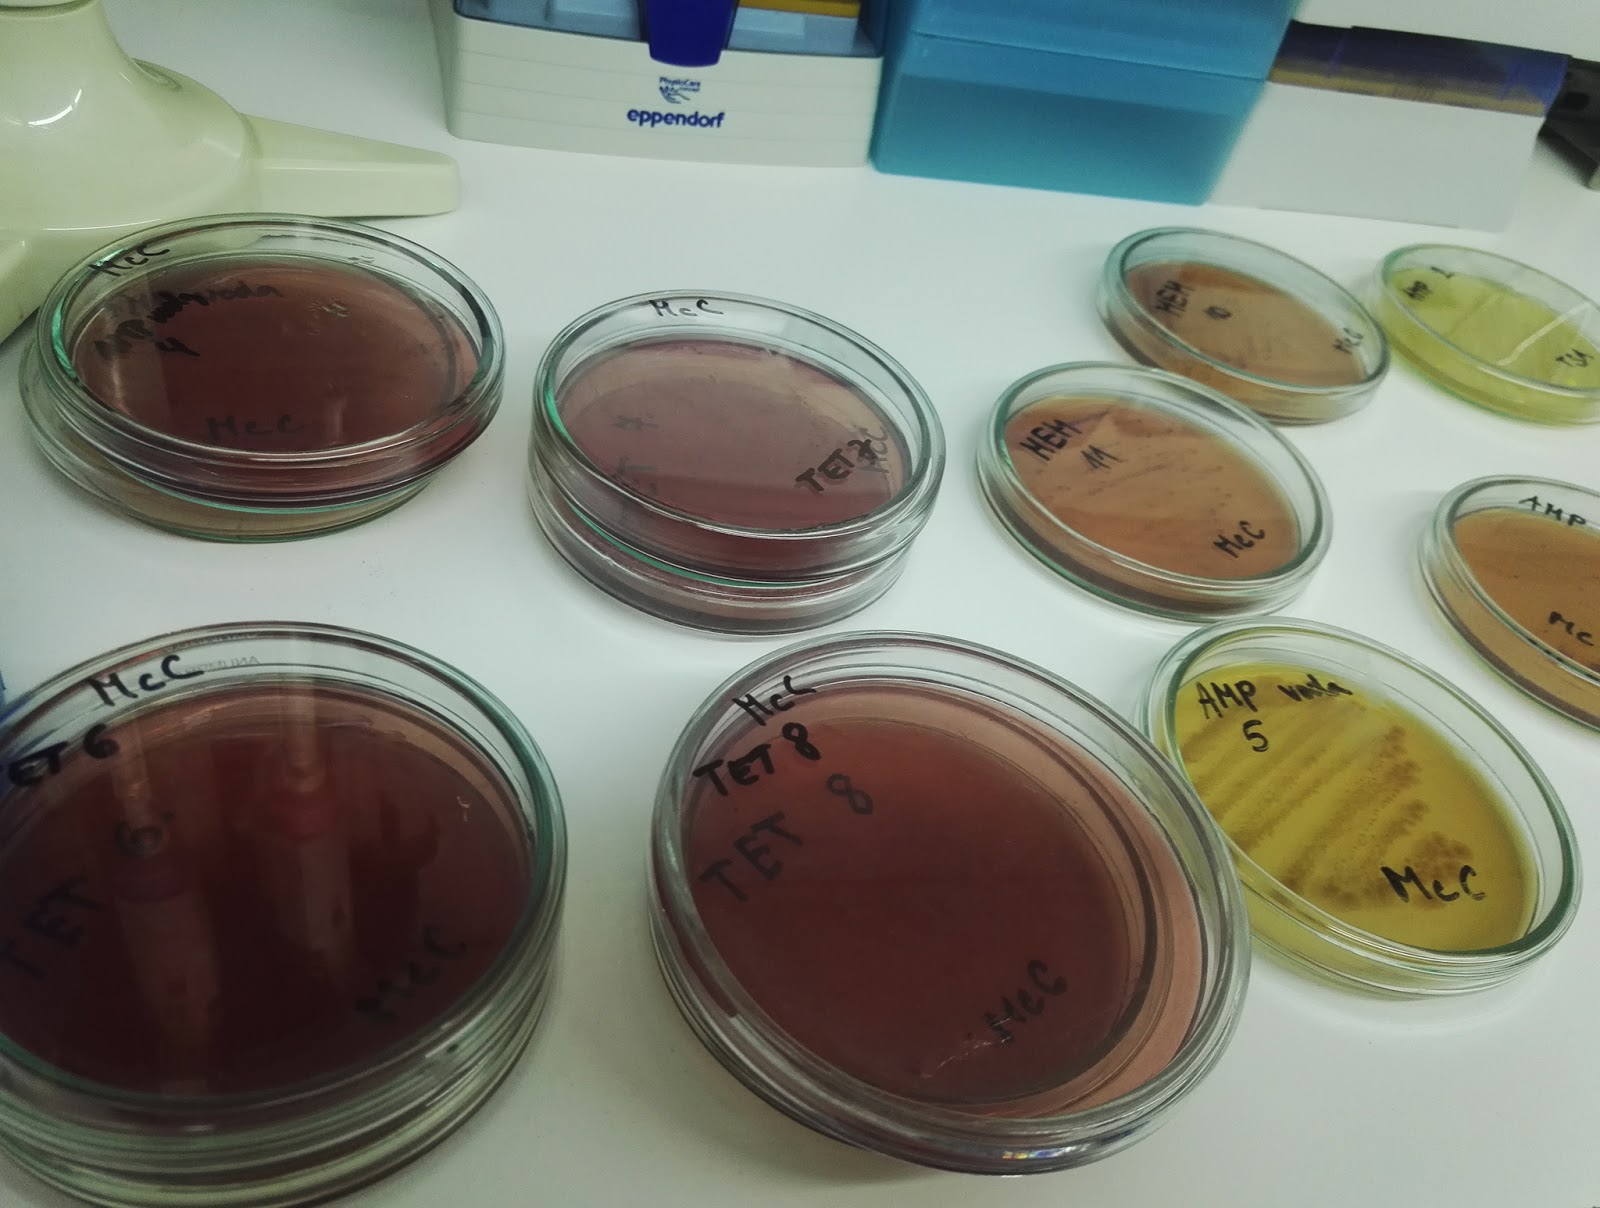

Posledný ročník na výške sa nesie v znamení diplomoviek a tak sa aj tie moje dni nesú v znamení kultivovania baktérií na živné pôdy.
Každý zvykne nadávať na odbor, ktorý začal študovať, no ja som spokojná :)
Síce sa mi téma diplomovky zmenila, nezúfam, bojujem :D
The last year on University is about diploma thesis, so my days are about cultivating bacteria on agar. A lot of student which I know are not ok with programme which they chose. But I am :)
Although my consultant changed the topic of my thesis, I am trying to be ok with that :D

Žiadne komentáre:
Zverejnenie komentára